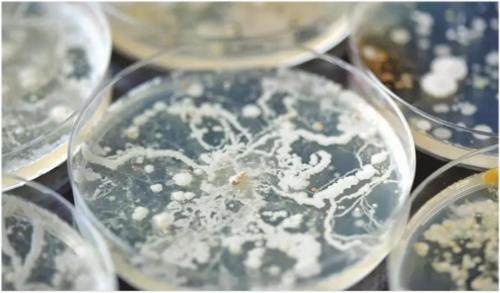

在地球的极端环境中,生命以超乎想象的形式展现其顽强与多样性。南极,这片被冰雪覆盖的大陆,最近有一项在深湖中隐藏的秘密由澳大利亚悉尼科技大学、荷兰皇家海洋研究所等多家机构联合开展的研究揭开。
古菌,作为生命的三大谱系之一,与细菌和真核生物共同构成了地球上的微生物世界。尽管在细胞结构和生物化学特征上与细菌有所不同,但在基因组结构和转录、翻译过程中的机制上,古菌却与真核生物更为接近。古菌的独特之处在于其细胞膜和细胞壁成分,这些成分在极端环境下表现出非凡的稳定性,使古菌能够在高温、高盐、高酸及厌氧等极端环境中生存。
南极深湖,以其极低的温度和极高的盐度,成为研究生命极限和适应性的天然实验室。在这里,古菌展现了惊人的生存能力,它们不仅能够在极端条件下存活,还进化出了独特的生存策略,如寄生行为。

研究人员在南极深湖中发现了一种特殊的古菌——南极纳米盐古菌,它们属于DPANN古菌(一类基因组和细胞极小的共生古菌) 这一支系。
DPANN古菌以其体型微小、基因组简化、代谢能力有限而著称, 长期以来,科学家们对它们如何在这种极端环境中生存充满了好奇。
通过先进的显微技术,包括活体荧光显微镜、低温光电子显微镜和冷冻电子断层扫描等,研究团队观察到了一种令人惊讶的现象:南极纳米盐古菌能够附着并侵入另一种噬盐古细菌——深湖古菌的细胞内,最终导致宿主细胞破裂死亡。这一过程与病毒的感染过程极为相似,显示出古菌在极端环境下的一种全新生存策略——寄生。

寄生行为在生物学中并不罕见,但古菌作为寄生者的发现却为微生物生态学带来了新的启示。南极纳米盐古菌通过寄生获得营养,这种生存策略不仅提高了它们在极端环境下的生存能力,还可能对南极生态系统的物质循环产生重要影响。
研究指出,南极纳米盐古菌在侵入宿主细胞后,会积累并在细胞内引发裂解,从而释放宿主细胞内的物质。这些物质随后成为其他微生物的食物来源,进而影响整个生态系统的物质循环。这一发现不仅深化了我们对古菌生态学功能的理解,也为研究其他极端环境中微生物的生存策略提供了新的视角。
古菌在生命起源和进化研究中的地位不可忽视。它们的基因组和转录、翻译机制与真核生物有许多相似之处,这使得古菌成为研究生命起源和早期进化的重要样本。DPANN古菌作为一类基因组极小、代谢能力有限的古菌,其寄生行为可能为生命在极端环境中的早期适应机制提供线索。
此外,古菌的寄生行为还可能揭示微生物群落内部复杂的相互作用网络。在极端环境中,微生物之间的相互作用对于维持生态系统的稳定性和功能至关重要。南极纳米盐古菌的寄生行为可能只是这一复杂网络中的一个环节,但其影响不容小觑。
古菌不仅在基础科学研究中具有重要意义,其应用潜力也在不断被挖掘。例如,古菌中某些酶类的耐高温特性使它们可在工业过程中成为重要的催化剂。此外,随着对古菌寄生行为的深入研究,我们或许能够从中发现新的抗生素和疾病治疗方法。这些发现不仅有助于解决当前医学领域的难题,还可能为生物技术的发展开辟新的道路。
未来,随着技术的不断进步和研究的深入,我们有望揭开更多关于古菌寄生行为的秘密。同时,这些发现也将为我们理解生命在极端环境中的适应机制和生态系统的稳定性提供重要线索。
南极深湖中的“微型捕食者”——南极纳米盐古菌的发现,为我们展示了一种全新的微生物生存策略。这一发现不仅挑战了我们对古菌的传统认知,也为微生物生态学和生命科学研究开辟了新的方向。在未来的研究中,科学家们期待能够进一步揭示古菌寄生行为的生物学机制和应用潜力,为探索生命的奥秘和保护地球生态系统贡献更多的智慧和力量。
通过这项研究,我们再次见证了生命的顽强与多样性。在地球的每一个角落,生命都在以它独有的方式展现着其无限的可能性和魅力。让我们继续探索、学习和保护这个美丽的星球,共同守护生命的奇迹。( 综合整理报道)(策划/黄李玲)





